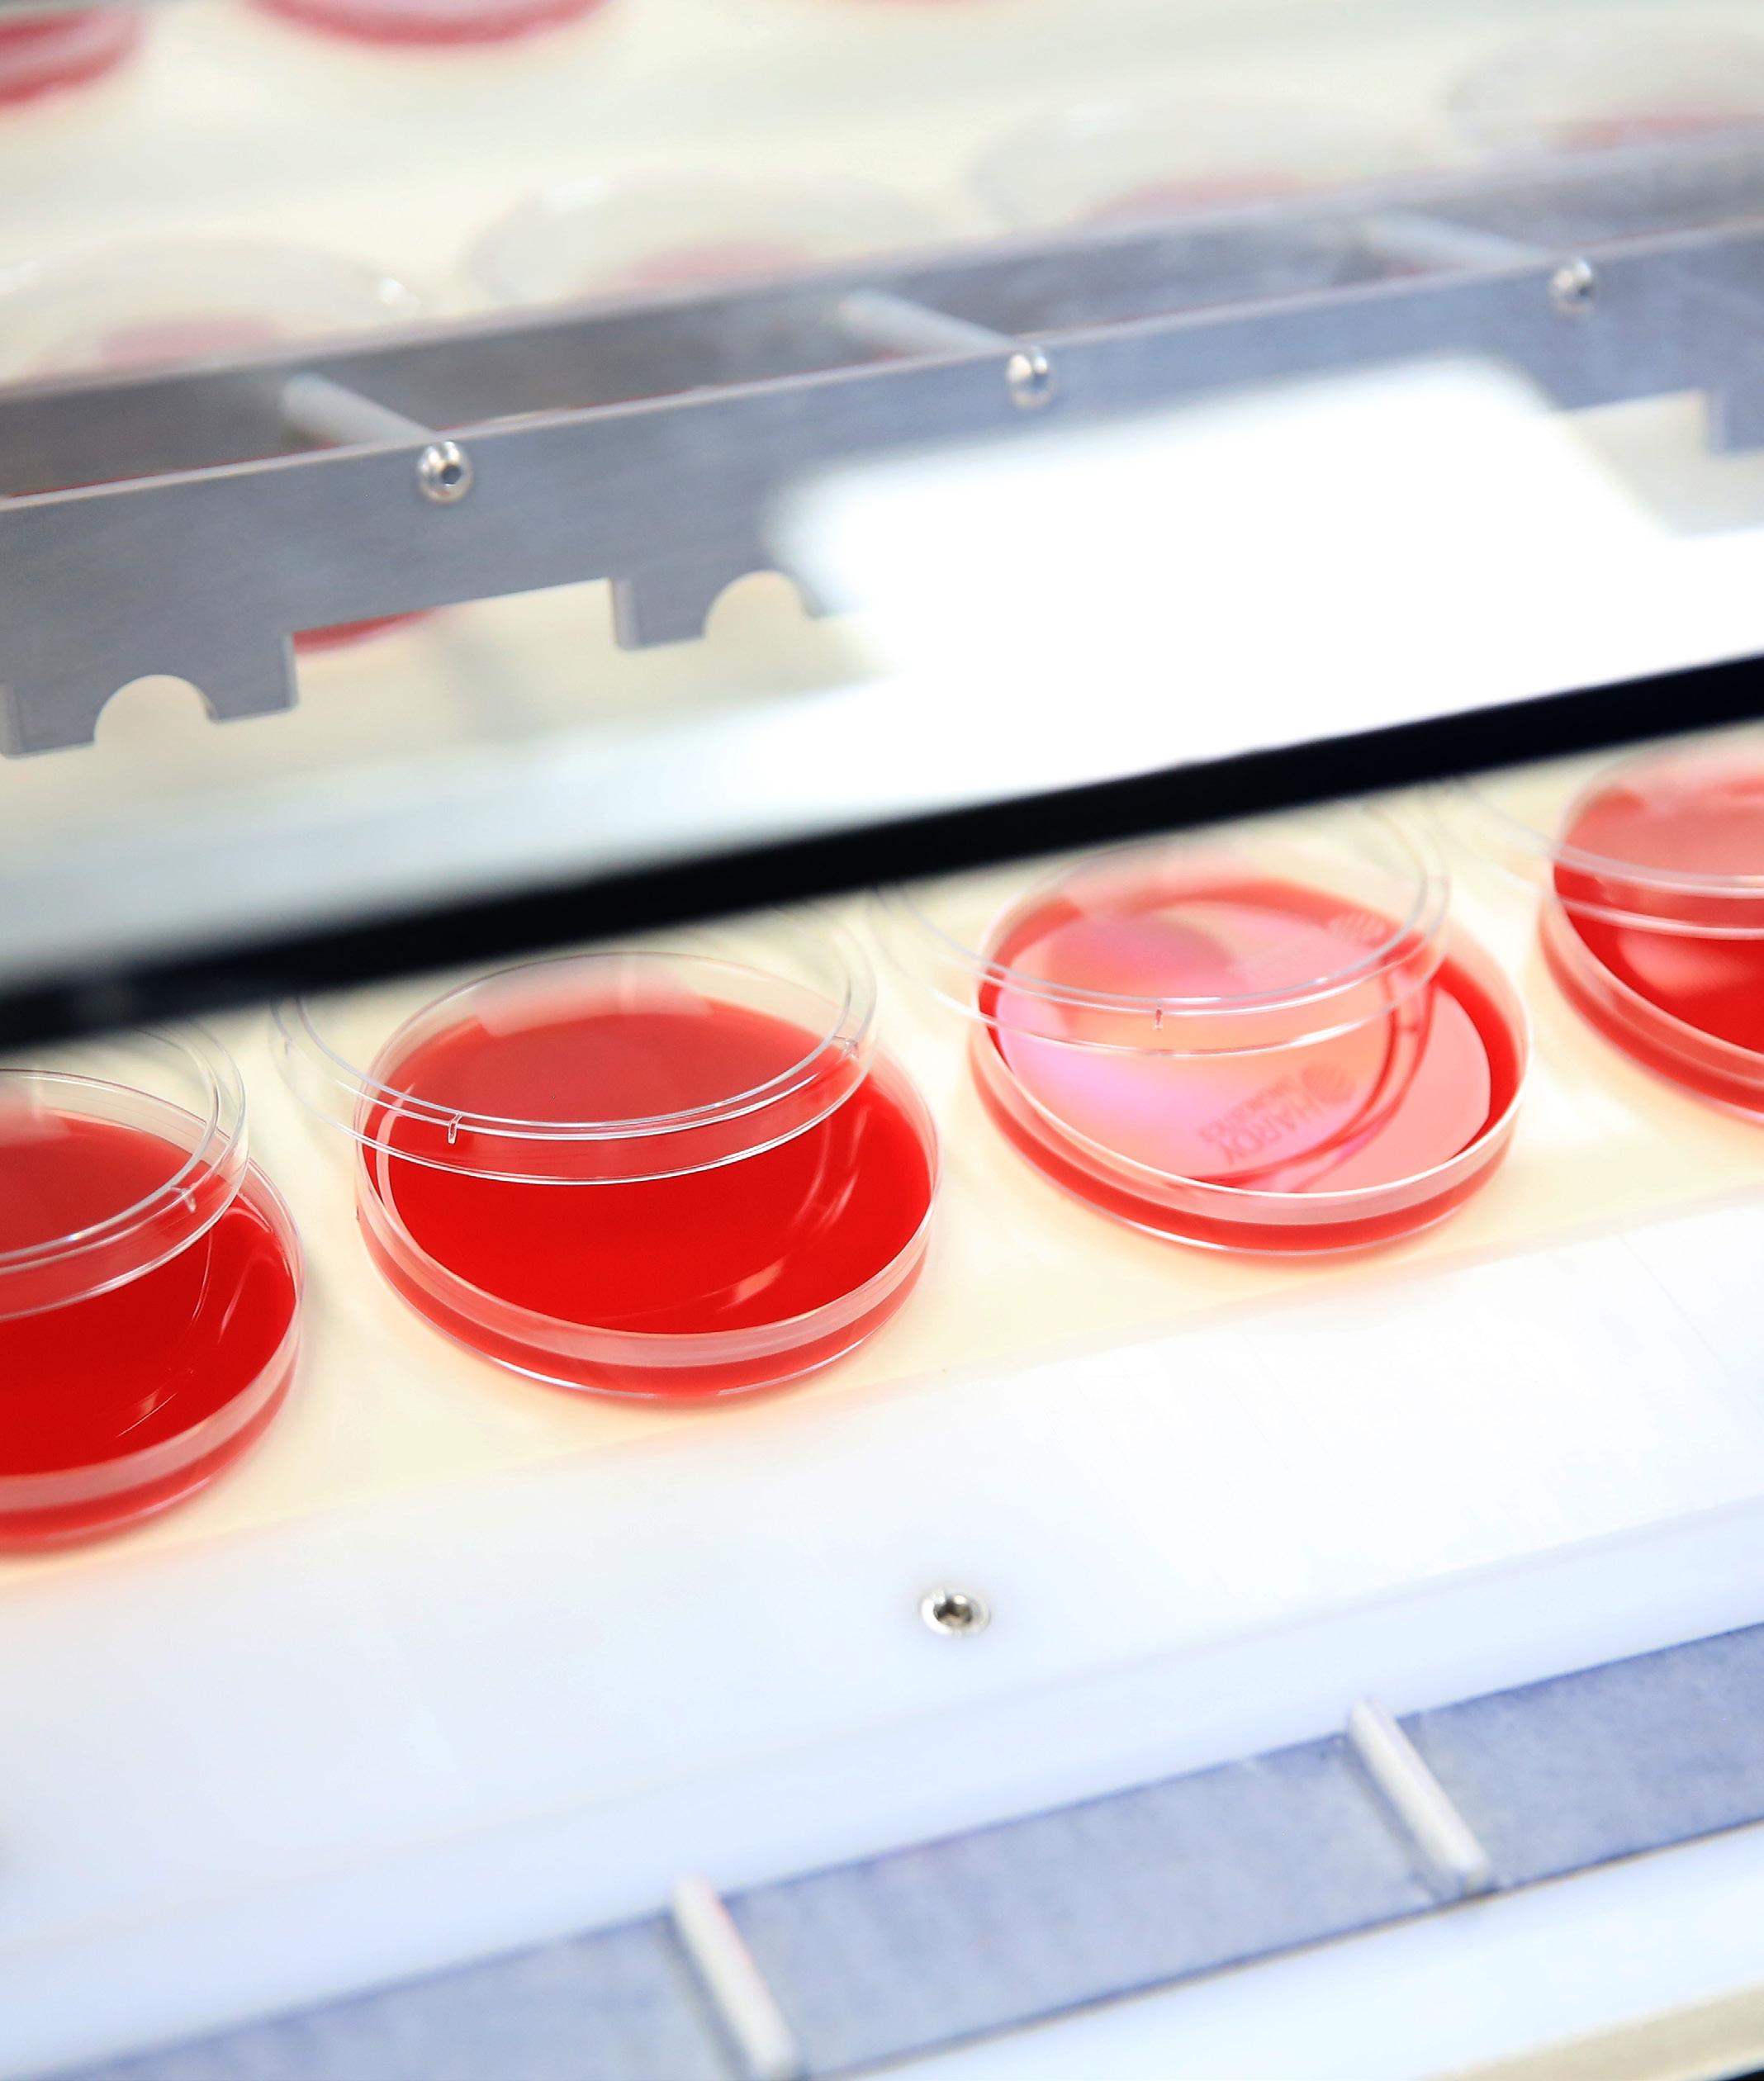

![]()





Hardy Diagnostics is the third-largest microbiological culture media manufacturer in the US, with a reputation for supplying quality products at a fair price with great customer service for the clinical, pharmaceutical, and food industries. We learn more from CEO, Chris Catani
Writer: Ed Budds | Project Manager: Callum Ovenstone

Since its inception in 1980, the company has transcended the ordinary, growing from a tworoom motel suite into a respected, global force in microbiology.
Initially, Founders Jay Hardy and Rob Shibata, worked tirelessly to
develop the business by night while working as microbiologists and medical technologists by day, before eventually dedicating themselves full-time to their exciting new endeavor.
“We believe in the power of
partnership, with our dedicated team and valued customers uniting to make a positive impact, one test at a time,” introduces CEO, Chris Catani.
Hardy’s story is one of resilience, partnership, and a relentless pursuit

of a healthier future for all.
“As we reflect on our journey, we stand at the forefront of microbiology, with a rich history shaping our commitment to quality, innovation, and social responsibility,” he sets out.
Over the last ten years, the US
healthcare industry has made a strong push toward automation, but so far, adoption has proven a slow and expensive process for hospitals and pharmaceutical manufacturers.
Following the direction of these trends, Hardy is evolving to establish
itself as both a supplier of traditional microbiology solutions as well as automation.
“Right now, the healthcare industry is a fast-moving, dynamic business with a plethora of opportunities,” Catani excites.
After moving from Chicago to Solvang, California, in 1996, Catani was searching for employment when a friend recommended working for Hardy.
He was swiftly hired as a salesperson, beginning his 30-year association and journey with the company.
Before relocating, he was a licensed medical technologist, managing a medical laboratory associated with Northwestern University’s hospital.
“In high school, I remember always being interested in biology,” he recalls fondly.
Hardy has recently invested in three outside technology companies, becoming shareholders in:
• Gradientech – A Swedish technology company that developed a rapid antimicrobial susceptibility machine for hospitals, QuickMIC®, transforming the time for test results from days to hours. The product is currently undergoing the FDA’s approval process.
• Mango – The US technology start-up that has developed a rapid platform for testing pharmaceutical drugs for sterility. This is increasing the turnaround time for a test from two weeks to just a few hours.
• NEMIS Technologies – A Swiss technology company that makes rapid tests for the environmental monitoring of food processing factories, thus improving food safety and providing protection from deadly pathogens like Listeria and Salmonella.
Hardy not only invests in these companies but has also become a true partner, manufacturing their products in the US and utilizing experienced sales strategies to sell them.

“As we reflect on our journey, we stand at the forefront of microbiology, with a rich history shaping our commitment to quality, innovation, and social responsibility”
– CHRIS CATANI, CEO, HARDY DIAGNOSTICS
Beginning a sales role was a different landscape at first, but Catani soon learned that being versed in the language of the lab gave him credibility with the customers.
“Back then, there were only four salespeople – me being one of them –and we have now grown to a current sales force of 25.”
During his years at Hardy, Catani has furthered his skillset and earned further certifications, such as becoming a registered microbiologist at the American College of Microbiology, specializing in pharmaceutical, medical device, and personal care microbiology.
“There has been plenty of on-thejob training throughout my career, where I’ve learned about customer care, enterprise resource planning (ERP) systems, websites, sales techniques, project management, accounting, income statements, balance sheets, and cash flow.
“Overall, I don’t attribute my success to being the smartest person in the room; I was always a very hard worker who got satisfaction through getting things done,” Catani passions.
Today, Hardy manufactures over 2,700 different products for use in the microbiology laboratory.
Alongside this, the company has grown to accommodate 420 employees, with two manufacturing sites – one in Santa Maria, California,

and another in Springboro, Ohio, as well as eight further distribution warehouses.

“Our main manufactured product is prepared culture media for the cultivation of microorganisms,” Catani explains.
“We manufacture around 2,000 different prepared culture media and reagents for manual microbiology, as well as being a distributor for approximately 30 other microbiology supply companies to fill gaps in our product offering portfolio,” he illustrates.
Some of the automated platforms Hardy offers include automated blood staining instruments, matrixassisted laser desorption/ionization
(MALDI) for rapid bacterial and fungal identification, rapid antimicrobial susceptibility testing (AST) platforms, and viable air samplers.
“We are committed to producing and distributing the finest products for the detection of microorganisms as we partner with our laboratory customers to diagnose and prevent disease.”
In terms of distributing its products, Hardy has access to a network of 10 distribution warehouses across the US – a distribution network that took 15 years to build.
As such, the company’s growing logistics network now includes facilities in Arizona, Washington, California, Utah, Texas, Iowa, Florida, North Carolina, Ohio, and New York.

Since 2004, TriForest Enterprises has been the packaging partner behind the polycarbonate containers used on Hardy Diagnostics products. More than 134 Hardy Diagnostics SKUs use TriForest autoclavable, non-leachable containers designed for microbiology. By introducing Tryptic Soy Broth in TriForest’s polycarbonate bottles, Hardy Diagnostics redefined its product offering and set a new industry benchmark. TriForest established the standard for safety, sterilization, and automation in regulated environments by replacing glass with purpose-built polycarbonate systems. Bottles, tubes, jars, vials. We make it all.
TriForest high performance containers provided the structural integrity that helped Hardy Diagnostics scale with distinctive, patented and trade dress protected packaging. Replacing fragile glass with shatter resistant, autoclavable polycarbonate delivered more than growth.
Eliminate bottlenecks. Precision geometries enable high speed automation.
Standardize logistics. Uniform, lightweight, and leakproof systems support global distribution.
Improve safety. Impact resistant resins remove glass related injuries.
Reduce cost and waste. Reusable systems lower breakage and scrap.






TriForest designs precision solutions that bridge R&D and industrial scale production.
Erlenmeyer & Culture Flasks: Optimized oxygen transfer with the patented DuoCAP® for sterile gas exchange in aerobic and anaerobic workflows.
Boston Round & Wide Mouth Bottles: Space efficient, impact resistant designs for high-speed filling and storage. These are the only polycarbonate bottles on the market that can be autoclaved with the cap fully tightened while achieving SAL 10-6 sterility assurance.
Serum Vials & Culture Tubes: Shatter resistant polycarbonate with glass like clarity for sampling and centrifugation.

We select high performance resins to meet specific chemical and thermal needs.
Polycarbonate: Non leaching, reusable, heavy duty, inert, and autoclavable for reliable aqueous solution production.
PETG: Gamma sterilized with tamper evident options for single use applications.
PET: Lightweight with high optical clarity.
Polypropylene: Engineered for chemical resistance.



www.triforest.com
https://www.linkedin.com/company/triforest-enterprises/

“This provides 90 percent of the country with next-day ground service of our products, lowering shipping costs for the end user, and increasing speed of delivery,” Catani continues.
“It is a logistical challenge as our products are temperature sensitive, fragile, Food and Drug Administration (FDA)-regulated, and with a short shelf life, but somehow, we get the products where they are needed at the right time,” he prides.
For Hardy, integrity always comes first when consulting with laboratory customers and distribution partners.
“We strive to grow business by providing superior service in the industry, and building lasting, fruitful partnerships,” expresses Catani.
“With an organization of Hardy’s size and complexity, you must also internally empower your managers to make decisions that help propel the business forward,” he adds.
As such, the company’s leadership comprises a team of individual experts, each bringing a unique set of skills and deep expertise in their respective fields.



“It is truly an honor for me to lead Hardy and fill the shoes left by our Founder, Jay Hardy. My job is to set the vision and make sure we stay on track throughout the next stages of our strategic plan”
– CHRIS CATANI, CEO, HARDY DIAGNOSTICS
“Our executive leadership team has approximately 200 years of combined experience in our market.”
In this way, Hardy knows the value of its trusted team members and seeks to both reward and empower them.
The company is 100 percent employee-owned by the people who work at the business, and shares are distributed annually to each employee.
The company serves a wide variety of labs across the world, including:
• Hospitals
• Medical clinics
• Research laboratories
• Reference laboratories
• Colleges and universities
• Pharmaceutical manufacturing
• Pharmacy compounders
• Food and beverage processors
• Personal care and cosmetics
• Water and wastewater testing
• Environmental laboratories
• Veterinarians
• BioTech


Additionally, if the company does well, employees’ share value increases, thus proving a substantial nest egg for retirement.
“We also offer quarterly profit sharing and a wonderful benefits package including medical assistance, vision care, a company gym, and numerous opportunities for recreation and exercise.”
“At Hardy, we’re dedicated to fostering an outstanding work environment that extends globally to diagnose and prevent disease, making a meaningful impact worldwide,” Catani acclaims.
Looking to the future, Hardy has set some ambitious sales targets for 2026 and is investing millions in expanding its manufacturing footprint in California by building more cleanrooms for culture media manufacturing and other projects requiring cleanrooms.
“This exciting expansion is needed in our California manufacturing campus as we have grown out of our existing manufacturing space,” Catani confirms.
In 2025, the company ended the year with $108,000,000 in sales revenue, and in 2026, the new goal is to eclipse this by reaching $116,000,000 in sales.
“That is a lot of petri plates to sell,
and we plan on capturing more sales revenue by increasing our market penetration, adding more sales specialists, and leveraging our distribution partners such as VWR, ThermoFisher, Medline, Thomas Scientific, and Cardinal Health,” he elaborates.
Elsewhere, Hardy also plans to introduce new products across its three main markets: clinical, pharmaceutical, and food microbiology.
“It is truly an honor for me to lead Hardy and fill the shoes left by our Founder, Jay Hardy. My job is to set the vision and make sure we stay on track throughout the next stages of our strategic plan,” he finishes boldly.


Tel: 800-266-2222
Sales@HardyDiagnosics.com